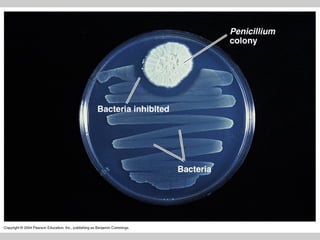

O documento descreve três tipos de transferência genética em bactérias: conjugação, transformação e transdução. A conjugação envolve a transferência de DNA entre bactérias através de pili. A transformação envolve a incorporação de fragmentos de DNA livre no meio no genoma bacteriano. A transdução envolve a transferência de DNA entre bactérias mediada por bactériófagos.